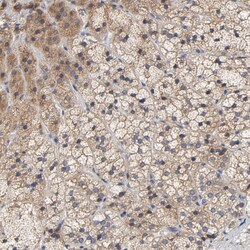
Invitrogen CCDC134 Polyclonal Antibody 100 &mu;L | Buy Online | Invitrogen&trade; | Fisher Scientific

missing translation for 'onlineSavingsMsg'
Learn More
Learn More
Invitrogen™ CCDC134 Polyclonal Antibody


Description
Immunogen sequence: LLALKNLAQL NDIHQQYKIL DVMLKGLFKV LEDSRTVLTA ADVLPDGPFP QDEKLKDAFS HVVENTAFFG DVVLRFPRIV HYYFDHNSNW NLLIRWGISF CNQTGVFNQG PHSPILSLMA QEL Highest antigen sequence identity to the following orthologs: Mouse - 96%, Rat - 95%.
The coiled-coil domain is a common protein motif that is often involved in protein oligomerization and is found in proteins such as transcription factors and intermediate filaments. One such protein is CCDC134, a recently identified secretory protein that has been found to inhibit the transcriptional activity of the Elk1 protein. Overexpression CCDC134 also inhibited the phosphorylation of Erk and JNK/SAPK but not p38 MAPK, while specific siRNA against CCDC134 activated Elk1 transcriptional activity and the phosphorylation of Erk and JNK/SAPK, suggesting a potential inhibiting role of CCDC134 in MAPK-mediated Elk1 transcription. CCDC134 is widely expressing in normal adult tissues, tumors, and cell lines.

Specifications
Specifications
| Antigen | CCDC134 |
| Applications | Immunohistochemistry (Paraffin), Western Blot |
| Classification | Polyclonal |
| Concentration | 0.1 mg/mL |
| Conjugate | Unconjugated |
| Formulation | PBS with 40% glycerol and 0.02% sodium azide; pH 7.2 |
| Gene | CCDC134 |
| Gene Accession No. | Q9H6E4 |
| Gene Alias | 2310042L06Rik; AW208859; Ccdc134; coiled-coil domain containing 134; coiled-coil domain-containing protein 134; dJ821D11.3 |
| Gene Symbols | CCDC134 |
| Show More |
Product Title
By clicking Submit, you acknowledge that you may be contacted by Fisher Scientific in regards to the feedback you have provided in this form. We will not share your information for any other purposes. All contact information provided shall also be maintained in accordance with our Privacy Policy.
Spot an opportunity for improvement?